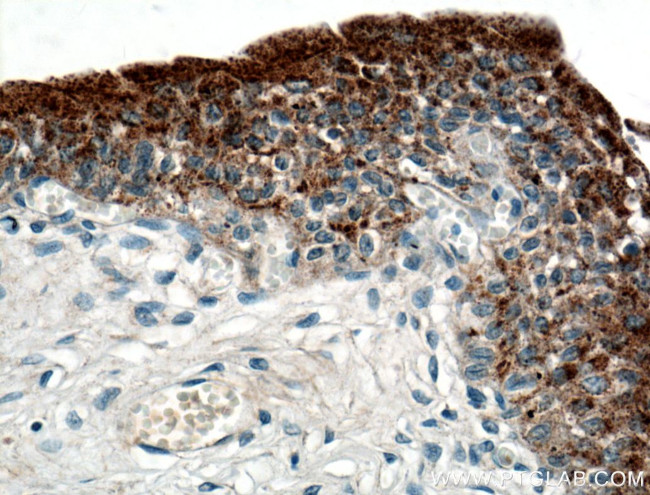
UPK2 Antibody in Immunohistochemistry (Paraffin) (IHC (P))

Search
Proteintech
UPK2 Polyclonal Antibody
{{$productOrderCtrl.translations['antibody.pdp.commerceCard.promotion.promotions']}}
{{$productOrderCtrl.translations['antibody.pdp.commerceCard.promotion.viewpromo']}}
{{$productOrderCtrl.translations['antibody.pdp.commerceCard.promotion.promocode']}}: {{promo.promoCode}} {{promo.promoTitle}} {{promo.promoDescription}}. {{$productOrderCtrl.translations['antibody.pdp.commerceCard.promotion.learnmore']}}
产品信息
21149-1-AP
种属反应
宿主/亚型
分类
类型
抗原
偶联物
形式
浓度
规格
纯化类型
保存液
内含物
保存条件
运输条件
产品详细信息
Immunogen sequence: TESLLVALP PCHLTGGNAT LMVRRANDSK VVTSSFVVPP CRGRRELVSV VDSGAGFTVT RLSAYQVTNL VPGTKFYISY LVKKGTATES SREIPMSTLP RRNMESIGLG MARTGGMVVI TVLLSVAMF (41-168 aa encoded by BC113900)
靶标信息
This gene encodes one of the proteins of the highly conserved urothelium-specific integral membrane proteins of the asymmetric unit membrane which forms urothelium apical plaques in mammals. The asymmetric unit membrane is believed to strengthen the urothelium by preventing cell rupture during bladder distention. The encoded protein is expressed in the peripheral blood of bladder cancer patients with transitional cell carcinomas.
仅用于科研。不用于诊断过程。未经明确授权不得转售。
生物信息学
蛋白别名: UP2; UPII; Uroplakin II; Uroplakin-2
基因别名: AW491716; UP2; UPII; UPK2
UniProt ID: (Human) O00526
Entrez Gene ID: (Human) 7379, (Mouse) 22269, (Rat) 689093